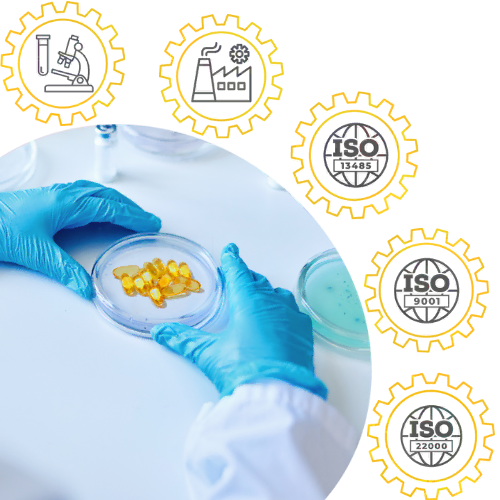

Zestaw 20 x Collaflex PLUS 13.000 + Omega 3 - Vitum forte, 60 kapsułek
- Suplement diety
- Zestaw zawiera 20 fiolek Collaflex PLUS 13.000 + Omega 3 - Vitum forte, 60 kapsułek
- Zawiera hydrolizowany kolagen typu I i III, witaminę C i ekstrakt z kłącza imbiru.
- Wygodna do stosowania, płynna forma


Zestaw 20 x Collaflex PLUS 13.000 + Omega 3 - Vitum forte
Suplement diety | Objętość netto: 20 x 25 ml + 60 kapsułek
Collaflex PLUS 13.000 to suplement diety o smaku porzeczkowym, w płynnej formie zawierający hydrolizowany kolagen typu I i III, witaminę C i ekstrakt z kłącza imbiru. 13 000mg kolagenu o bardzo dobrej biodostępności to najwyższa zawartość kolagenu na rynku w formie płynnej*
* Wśród preparatów na stawy w formie płynnej w okresie VI2023 do V2024 wg. PEX 05.2024




CO DOSTARCZA DZIENNA PORCJA COLLAFLEX PLUS 13 000 ( 1 FIOLKA )?
Hydrolizowany kolagen typu I i III 13 000mg
Kolagen typu I to najbardziej powszechnie występujący rodzaj kolagenu w organiźmie. Odpowiada za elastyczność i wytrzymałość tkanki łącznej. Stanowi fundament budowy ścięgien, ale też skóry i kości. Kolagen typu III tworzy włókna tkanki łącznej właściwej siateczkowej, dzięki czemu zapewnia elastyczność i jędrność tkanek.
Witamina C 80mg
Pomaga w prawidłowej produkcji kolagenu w celu zapewnienia właściwego funkcjonowania kości oraz chrząstki. Pomaga również w ochronie komórek przed stresem oksydacyjnym, a także przyczynia się do utrzymania prawidłowego metabolizmu energetycznego.
Ekstrakt z kłącza imbiru 30mg
Przyczynia się do zwiększenia witalności.

DLACZEGO WARTO DBAĆ O CHRZĄSTKĘ STAWOWĄ?


DLA KOGO JEST COLLAFLEX PLUS 13000?
OSOBY STARSZE
OSOBY Z NADWAGĄ
OSOBY Z KONTUZJAMI STAWÓW
OSOBY AKTYWNE FIZYCZNIE / SPORTOWCY

Marka Collaflex została laureatem
tytułu Dobra Marka 2024
w kategorii: Suplementy diety

Zastosowanie:
Produkt polecany jest osobom dorosłym dbającym o utrzymanie prawidłowej kondycji chrząstki stawowej i zdrowych kości, zwłaszcza osobom uprawiającym sport.
Zalecane spożycie:
Dorośli - 1 fiolka (25 ml) raz dziennie. Wstrząsnąć przed spożyciem. Produkt gotowy do spożycia bezpośrednio z fiolki, bez konieczności rozcieńczania w innych płynach. Nie należy przekraczać zalecanej porcji do spożycia w ciągu dnia. Suplementy diety nie mogą być stosowane jako substytut (zamiennik) zróżnicowanej diety. Utrzymanie prawidłowego stanu zdrowia wymaga zrównoważonego odżywiania i prowadzenia zdrowego trybu życia.
Składniki:
Woda, hydrolizowany kolagen typu I i III, regulator kwasowości: kwas cytrynowy, sproszkowany koncentrat soku z buraka ćwikłowego, kwas L-askorbinowy (witamina C), aromat, substancja konserwująca: benzoesan sodu, ekstrakt z kłącza imbiru (Zingiber o_cinale), substancja konserwująca: sorbinian potasu, substancja słodząca: sukraloza.
Suplement diety Collaflex PLUS 13.000 zawiera substancje słodząca.
Dzienna porcja (1 fiolka – 25 ml) zawiera:
*% referencyjnej wartości spożycia
Przechowywanie:
Przechowywać w temperaturze pokojowej, w suchym i ciemnym miejscu. Suplementy diety powinny być przechowywane w sposób niedostępny dla małych dzieci.

Omega 3-Vitum forte, 60 kapsułek
Suplement diety
Wsparcie pracy serca,
mózgu i prawidłowego widzenia
oraz pomoc w utrzymaniu właściowego poziomu trójglicerydów we krwi1
11Kwas eikozapentaenowy (EPA) i kwas dokozaheksaenowy (DHA) przyczyniają się do prawidłowego funkcjonowania serca. Korzystne działanie występuje w przypadku spożywania 250 mg EPA i DHA dziennie. Ponadto kwas dokozaheksaenowy (DHA) przyczynia się do utrzymania prawidłowego funkcjonowania mózgu oraz przyczynia się do utrzymania prawidłowego widzenia. Korzystne działanie występuje w przypadku spożywania 250 mg DHA dziennie. DHA i EPA pomagają w utrzymaniu prawidłowego poziomu trójglicerydów we krwi. Korzystne działanie występuje w przypadku spożywania 2 g EPA i DHA dziennie. Nie należy przekraczać poziomu uzupełniającego dziennego spożycia wynoszącego 5 g EPA i DHA łącznie.



Wysoka zawartość kwasów tłuszczowych Omega-3,
aż 1100 mg oleju rybiego 33% EPA i 22% DHA
Co wyróżnia
Omega-3 Vitum forte?

- Aż 1100mg oleju rybiego z całych, małych ryb zimnowodnych
- Pomoc w prawidłowej pracy serca (EPA i DHA)
- Wsparcie dla właściwego funkcjonowania mózgu i prawidłowego widzenia (DHA)
- Korzystny wpływ na ochronę komórek przed stresem oksydacyjnym (witamina E)
- Wysoka jakość i koncentarcja kwasów tłuszczoych Omega-3 - aż 65%, w tym 33% EPA i 22% DHA
- Bez barwników i konserwantów
- Wyprodukowano w polskiej firmie Oleofarm Sp. z o.o.
Kto może odnieść korzysći z suplementacji
kwasami OMEGA-3?
sportowcy
osoby starsze
kobiety w ciąży
osoby, które chcą zadbać o prawidłową kondycję serca, mózgu i wzroku
Dobry skład
od OLEOFARM
DZIENNA PORCJA zawiera: | 1 kapsułka | 2 kapsułki | 4 kapsułki |
Olej rybi (65% kwasów tłuszczowych omega-3), w tym: | 1100 mg | 2200 mg | 4400 mg |
33% kwasu eikozapentaenowego (EPA) | 363 mg | 726 mg | 1452 mg |
22% kwasu dokozaheksaenowego (DHA) | 242 mg | 484 mg | 968 mg |
10% innych kwasów omega-3 | 110 mg | 220 mg | 440 mg |
Witamina E | 12 mg (100%*) | 24 mg (200%*) | 48 mg (400%*) |
*% referencyjnej wartości spożycia
Nie należy przekraczać zalecanej porcji do spożycia w ciągu dnia. Suplementy diety nie mogą być stosowane jako substytut (zamiennik) zróżnicowanej diety. Utrzymanie prawidłowego stanu zdrowia wymaga zrównoważonego odżywiania i prowadzenia zdrowego trybu życia.
Składniki:
olej rybi, żelatyna (składnik otoczki), substancja utrzymująca wilgoć: glicerol, octan DL-alfa-tokoferylu.

Wysoka jakość
od OLEOFARM

Omega-3 Vitum Forte jest produkowane w firmie Oleofarm we Wrocławiu, przy zachowaniu najwyższych standardów jakościowych tj. np ISO 9001, ISO 22000 oraz ISO 13485.





Zastosowanie:
Dorośli - 1-2 kapsułki dziennie w celu wsparcia pracy serca, mózgu i prawidłowego widzenia, 2 kapsułki dwa razy dziennie dla utrzymania prawidłowego poziomu trójglicerydów we krwi. Nie należy przekraczać zalecanej porcji do spożycia w ciągu dnia. Suplementy diety nie mogą być stosowane jako substytut (zamiennik) zróżnicowanej diety. Utrzymanie prawidłowego stanu zdrowia wymaga zrównoważonego odżywiania i prowadzenia zdrowego trybu życia.
Przechowywanie:
Przechowywać w temp. pokojowej, w suchym i ciemnym miejscu. Suplementy diety powinny być przechowywane w sposób niedostępny dla małych dzieci.